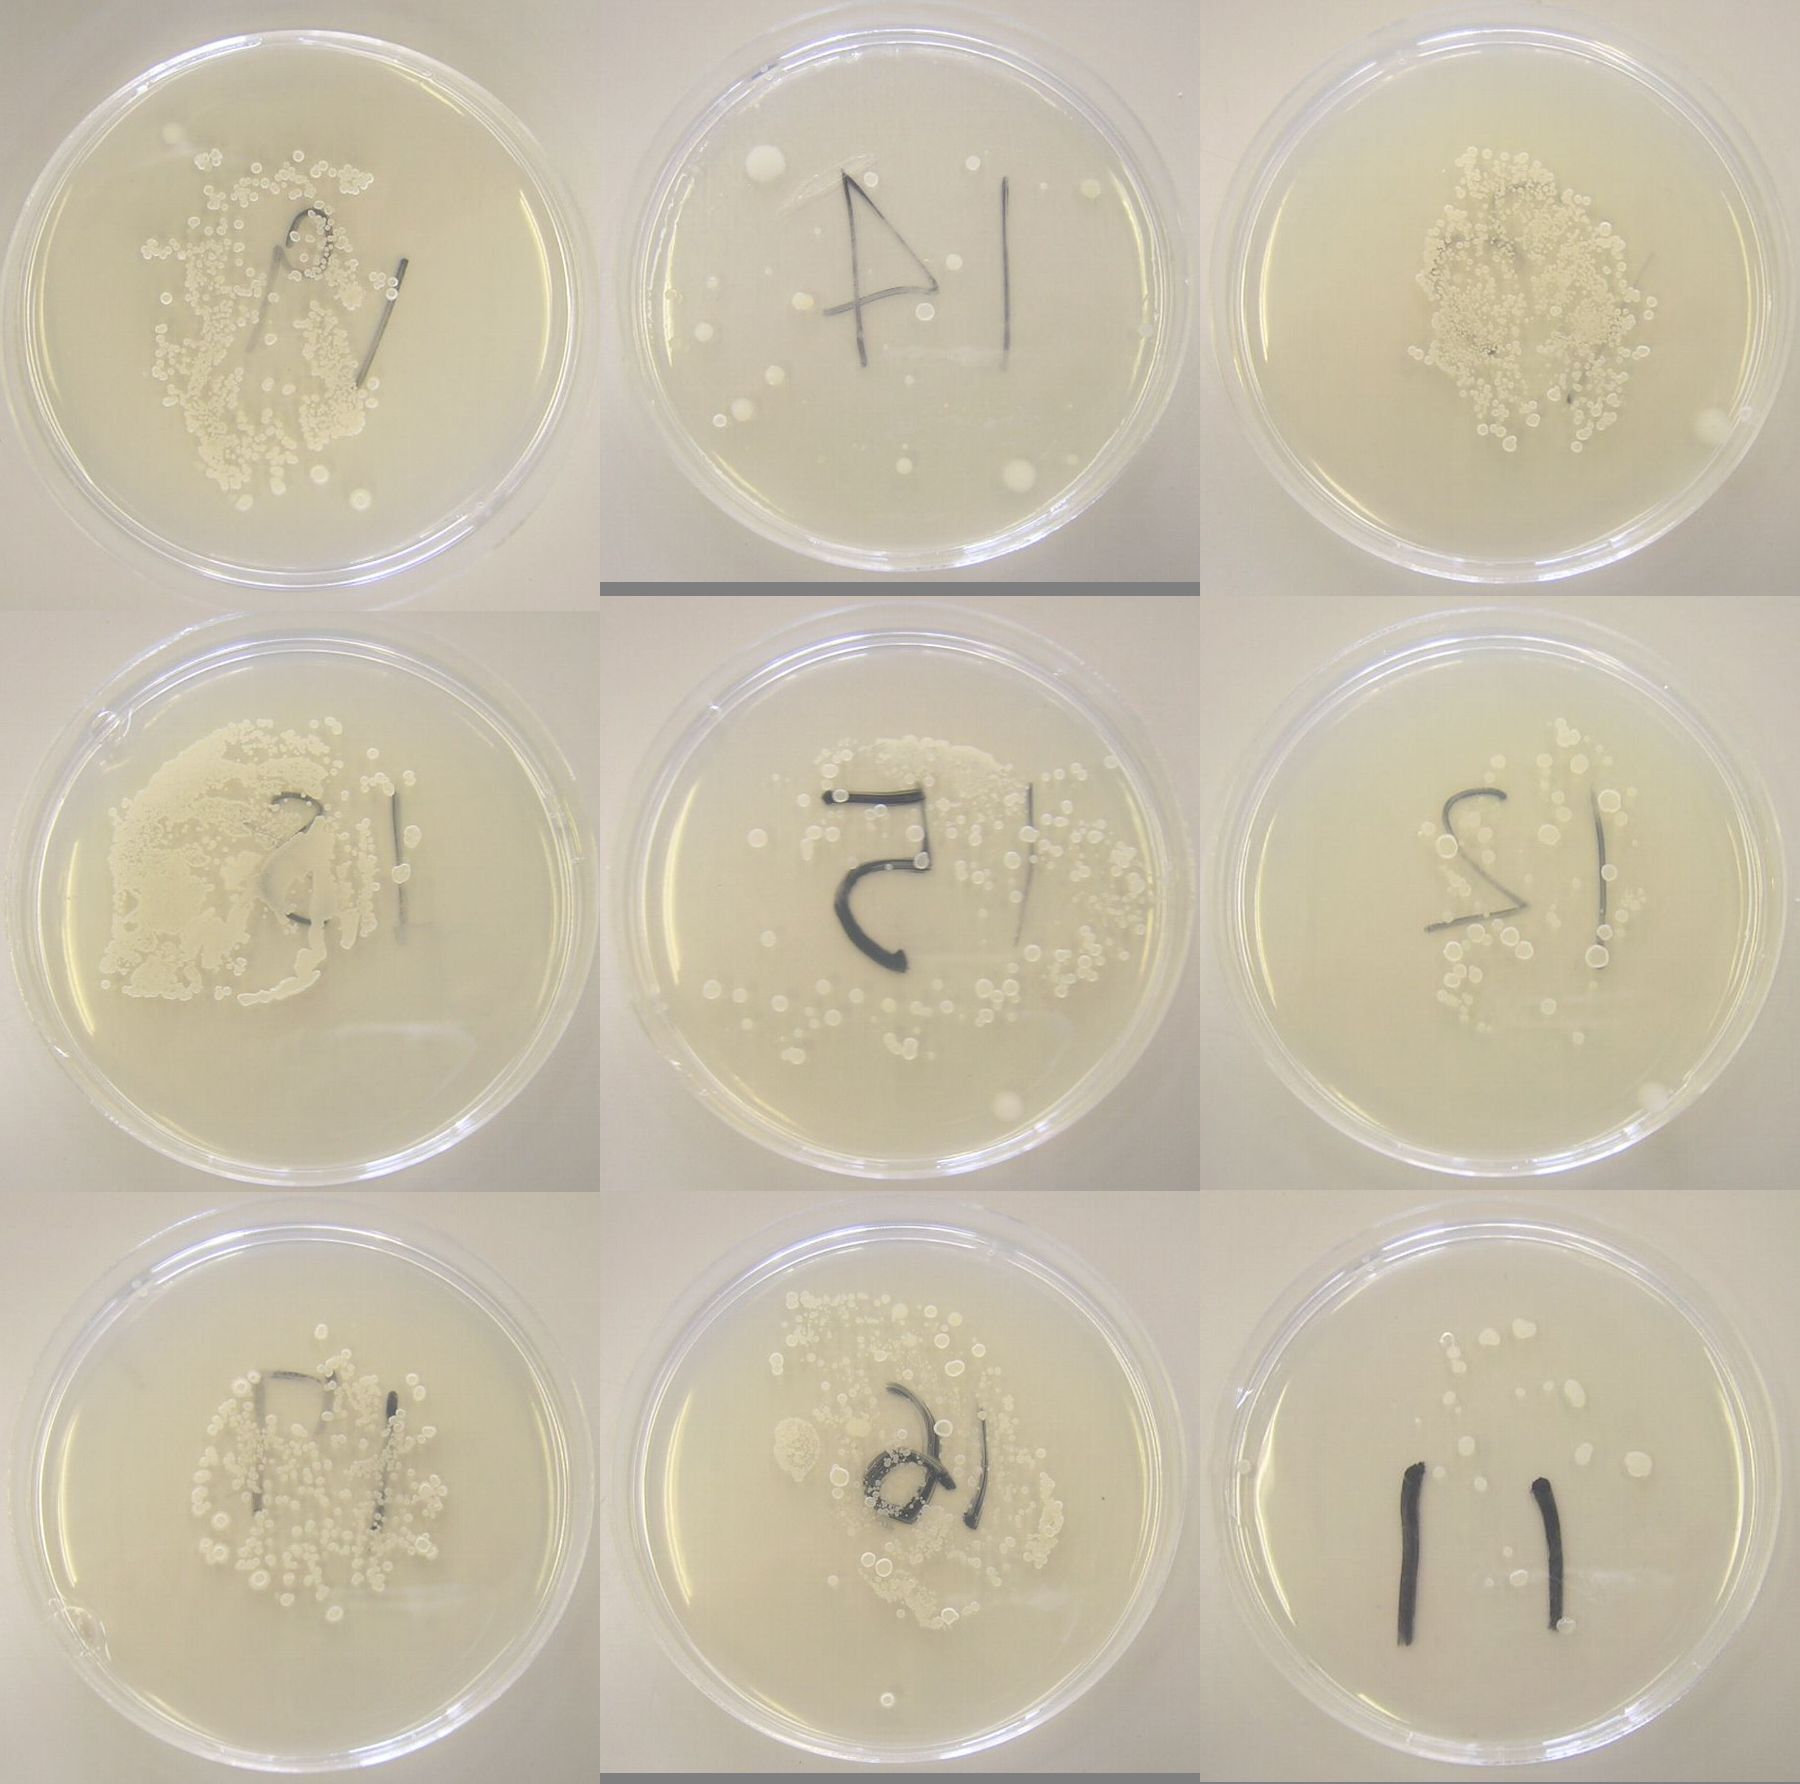
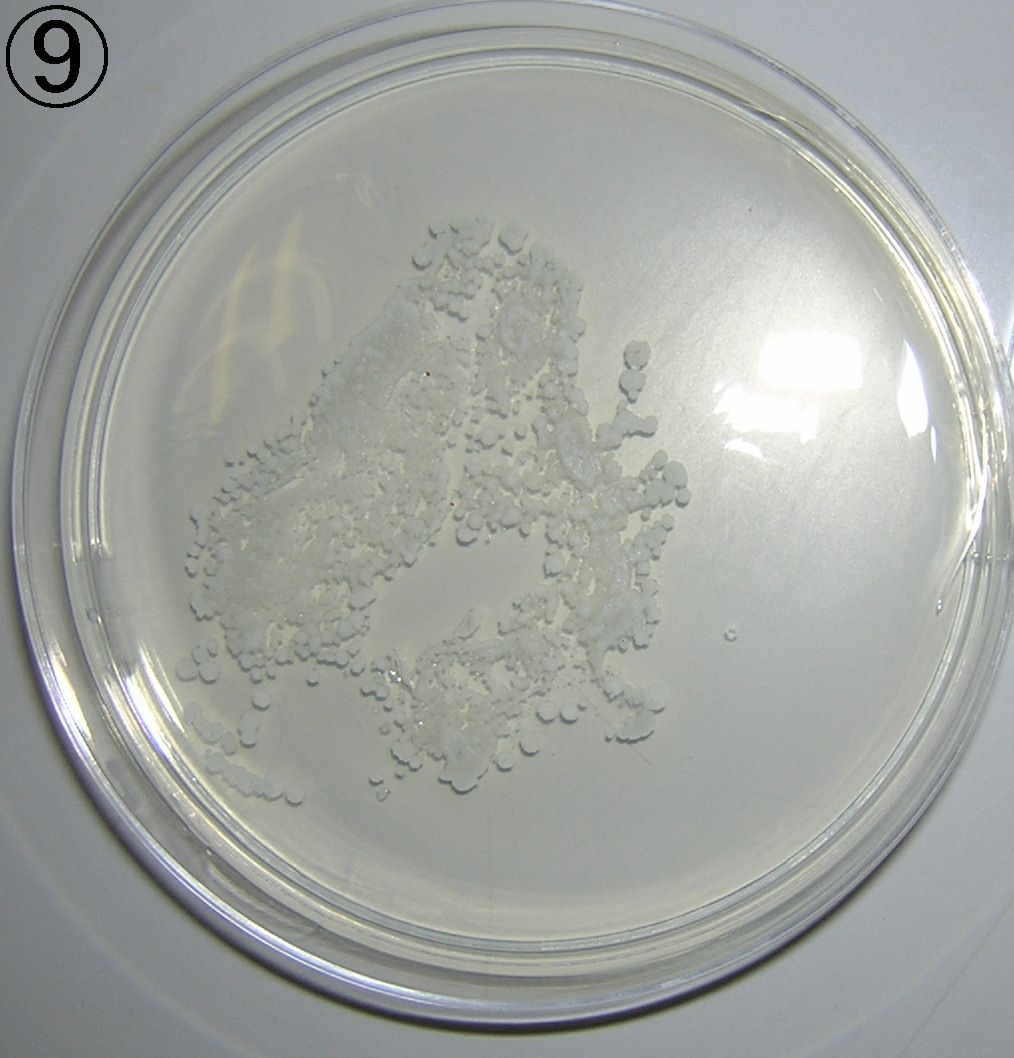
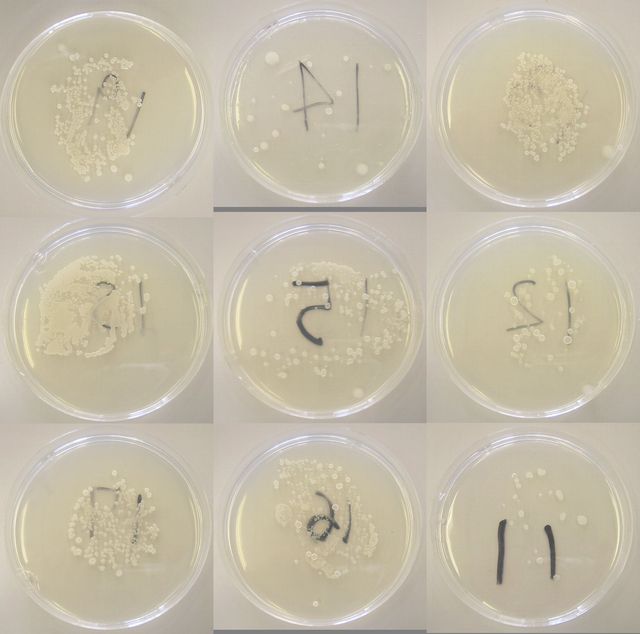

これらのキーワードがハイライトされています:04
1月末†
ようやく散布試験を開始したでよ〜
- 散布条件
- 今回が全くの初散布。5:30から30分空運転(ダクト内の水蒸気とばし、らしい)。6:00から1時間運転。散布量は5g。
- 飛散テスト
- 1/30(水)の16時頃に培地の蓋を開け温室内に設置。翌朝、回収して35℃24時間培養。
- 付着テスト
- 1/31(木)の9時頃に胸の高さの小葉(先端部分)を培地に押しつけるスタンプテスト。培養は35℃24時間。
- 結果の所感
- 1-9を見ると思ったより均等に飛散している。付着量は結構、偏っているが、サンプリングの問題かも。
- 次回は高さを2〜3水準にしてみるかね。
バラでボトキラーのテスト中。
温湯暖房の温室で、東海物産の散布機を使っている。
とりあえず、付着テストから始める予定。
シクラメンで付着テスト*1をしたサンプル
コメント欄†
- あいやー Sekizuka --
書式をほとんど忘れてしまったがなー
- きれいに培養できるのですね 苺FUJISAWA --
あの、思ったのですが、ダクト散布(もしかして放飼)の効果を寒天培地で確認できるのだなあ。
でも、これが水和剤の散布で同じ事をするとどうなるのだろう?
何となく雑菌だらけ、って事になるのかな?
菌類も、やはり散布ではなく放飼という概念で対処は必要かな、と思う。
どんなものでしょう?
ところで、まる9の写真でいくつくらい胞子が付着したのかも気になります。
- 増量剤 苺FUJISAWA --
なんか適当な増量剤で、ファブリーズみたいに霧吹きでシュシュという具合になると良いなあ。
菌類は、それなりの散布・放飼方法があって良いと思うのです。
- >2 Sekizuka --
水和剤って「ボトキラー水和剤」ってことですよね?
それなら、普通に培養できると思います。
菌類(この場合は芽胞の付着数)は数が膨大なので、幾つと言われても難しいのですが、↓の2ページ目辺りが参考になるかと。
http://www.mmm.co.jp/hc/microbiology/petrifilm/pdf/MIC-002-G.pdf
- >3 Sekizuka --
え〜っと、何を訊かれているのかイマイチ把握しかねているのですが、、、
ボトキラーはそもそも散布剤として開発されたので、散布は全然可能です。
水和剤なので水で希釈して使うだけです。
それが何故、ダクト散布になったかというと作用機作上、「付着した部分
にしか効かない」=「次々に新芽が出てくる作物は、その都度散布が必要」
ということで開発されました。
逆に言うと新芽がそれほど増えないタイプの作物なら、散布で十分です。
- 5の補足 Sekizuka --
私が今回、わざわざ付着テストなどをしているのは、1つにはメーカーから
資材を借りて行っているので、多少なりとも「格好がつく(つきやすい)」
方が良いから、と言うのがあります。
また、バラの場合、データが少ないので散布頻度や散布量を調整する準備、
でもあります。(ダクトがじゃまなので散布機のダクトを外して角度調整
ぐらいでどうにかならないか、とか)
- >5 菅原@NARC --
3のFUJISAWAさんのご意見は、天敵昆虫のイメージ(放飼)で、天敵微生物もスポット散布で勝手に増殖して病害を防いでくれたらいいのに、ということかと思います。
ただしボトキラーの場合は、あくまで病害予防剤であるほか、5のように「付着した部分にしか効かない」とのことで、ハウス内全体にくまなく散布することが重要になります。
なお、「ボトキラー/ダクト内投入」のページがあるので、ご覧ください。
ページ末†